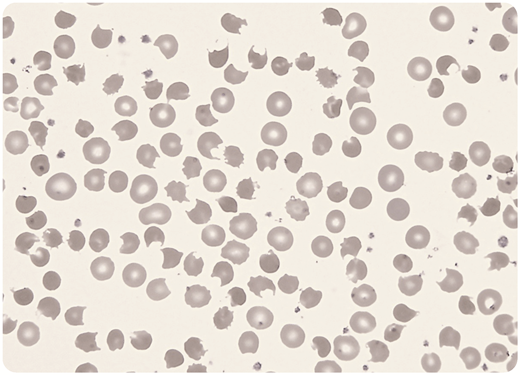
A 19-year-old man presented to the emergency department having taken an overdose of medications. On examination he was agitated and tachycardic and appeared icteric with central cyanosis. Pulse oximetry indicated an oxygen saturation of 86%, which did not improve with high-flow oxygen therapy. The full blood count showed hemoglobin 91 g/L, white blood cells 12.3 × 109/L, platelets 341 × 109/L, and reticulocytes 295 × 109/L. The blood film showed very prominent bite cells (keratocytes), with some red cells showing multiple bites (May-Grunwald Giemsa stain; original magnification ×500). An acute oxidant-induced hemolysis was considered, and the blood methemoglobin level was 30.8% (normal < 2%). A subsequent G6PD assay was normal. On further questioning, he admitted to taking a cocktail of drugs, including 5.6 g of dapsone, which was missing from his grandmother’s medicine supply. / Dapsone (diaminodiphenyl sulfone) is a compound that has antibiotic, antiparasitic, and anti-inflammatory properties; it has been used for many years in clinical medicine at doses of 50 to 100 mg daily. Even at these doses it can cause a mild chronic oxidative hemolysis. The amine metabolites of dapsone are capable of oxidation of heme iron, resulting in acquired methemoglobinemia and hemoglobin denaturation forming Heinz bodies. These precipitates are removed by splenic macrophages, forming bite cells that are readily identified in the blood film. The persistent hypoxemia, despite oxygen therapy, is an important finding in methemoglobinemia. He was treated with IV methylene blue, blood transfusion, and supportive care and made a full recovery.

A 19-year-old man presented to the emergency department having taken an overdose of medications. On examination he was agitated and tachycardic and appeared icteric with central cyanosis. Pulse oximetry indicated an oxygen saturation of 86%, which did not improve with high-flow oxygen therapy. The full blood count showed hemoglobin 91 g/L, white blood cells 12.3 × 109/L, platelets 341 × 109/L, and reticulocytes 295 × 109/L. The blood film showed very prominent bite cells (keratocytes), with some red cells showing multiple bites (May-Grunwald Giemsa stain; original magnification ×500). An acute oxidant-induced hemolysis was considered, and the blood methemoglobin level was 30.8% (normal < 2%). A subsequent G6PD assay was normal. On further questioning, he admitted to taking a cocktail of drugs, including 5.6 g of dapsone, which was missing from his grandmother’s medicine supply.
Dapsone (diaminodiphenyl sulfone) is a compound that has antibiotic, antiparasitic, and anti-inflammatory properties; it has been used for many years in clinical medicine at doses of 50 to 100 mg daily. Even at these doses it can cause a mild chronic oxidative hemolysis. The amine metabolites of dapsone are capable of oxidation of heme iron, resulting in acquired methemoglobinemia and hemoglobin denaturation forming Heinz bodies. These precipitates are removed by splenic macrophages, forming bite cells that are readily identified in the blood film. The persistent hypoxemia, despite oxygen therapy, is an important finding in methemoglobinemia. He was treated with IV methylene blue, blood transfusion, and supportive care and made a full recovery.
A 19-year-old man presented to the emergency department having taken an overdose of medications. On examination he was agitated and tachycardic and appeared icteric with central cyanosis. Pulse oximetry indicated an oxygen saturation of 86%, which did not improve with high-flow oxygen therapy. The full blood count showed hemoglobin 91 g/L, white blood cells 12.3 × 109/L, platelets 341 × 109/L, and reticulocytes 295 × 109/L. The blood film showed very prominent bite cells (keratocytes), with some red cells showing multiple bites (May-Grunwald Giemsa stain; original magnification ×500). An acute oxidant-induced hemolysis was considered, and the blood methemoglobin level was 30.8% (normal < 2%). A subsequent G6PD assay was normal. On further questioning, he admitted to taking a cocktail of drugs, including 5.6 g of dapsone, which was missing from his grandmother’s medicine supply.
Dapsone (diaminodiphenyl sulfone) is a compound that has antibiotic, antiparasitic, and anti-inflammatory properties; it has been used for many years in clinical medicine at doses of 50 to 100 mg daily. Even at these doses it can cause a mild chronic oxidative hemolysis. The amine metabolites of dapsone are capable of oxidation of heme iron, resulting in acquired methemoglobinemia and hemoglobin denaturation forming Heinz bodies. These precipitates are removed by splenic macrophages, forming bite cells that are readily identified in the blood film. The persistent hypoxemia, despite oxygen therapy, is an important finding in methemoglobinemia. He was treated with IV methylene blue, blood transfusion, and supportive care and made a full recovery.
For additional images, visit the ASH Image Bank, a reference and teaching tool that is continually updated with new atlas and case study images. For more information, visit http://imagebank.hematology.org.
This feature is available to Subscribers Only
Sign In or Create an Account Close Modal